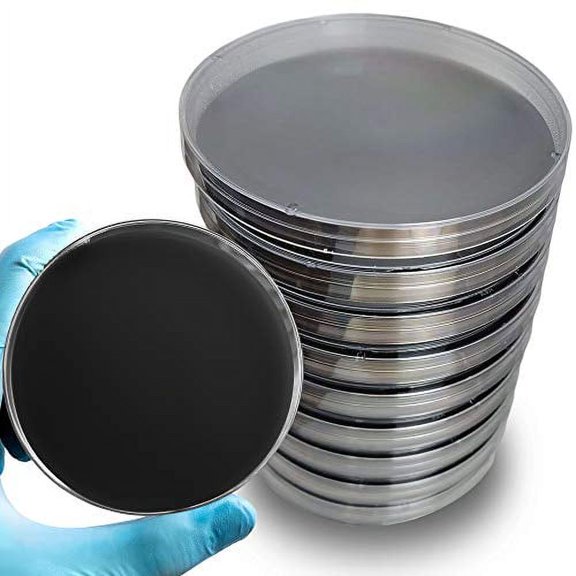
Pre-Poured Black Malt Extract Agar Plates Includes Both Black Dye & Charcoal for Enhanced Culture Visualization - Excellent Growth Medium - Great for Mushrooms & Science Projects$$Other

Nutrient Agar(83)
Uses item details. Price when purchased online
BulkSupplements Agar Agar Powder, Food-Grade Thickener, Gluten-Free, 500g, 125 Servings From $14.97

Sponsored
From$1497
BulkSupplements Agar Agar Powder, Food-Grade Thickener, Gluten-Free, 500g, 125 Servings
84.3 out of 5 Stars. 8 reviews
Save with
Agar Variety Kit by Evviva Sciences - Prepoured Potato Dextrose Agar, Malt Extract Agar, & Potato Dextrose Agar w/Activated Charcoal - Premium Performance - Great for Mushrooms & Science Projects $36.99

Sponsored
$3699
current price $36.99Agar Variety Kit by Evviva Sciences - Prepoured Potato Dextrose Agar, Malt Extract Agar, & Potato Dextrose Agar w/Activated Charcoal - Premium Performance - Great for Mushrooms & Science Projects
25 out of 5 Stars. 2 reviews
Agar Agar Powder 8 oz - Vegan (Vegetarian) Gelatin - Gluten Free Unflavored - 151 Servings Per Bag $14.99 Was $16.99

Sponsored
Now$1499
current price Now $14.99, Was $16.99$16.99
Agar Agar Powder 8 oz - Vegan (Vegetarian) Gelatin - Gluten Free Unflavored - 151 Servings Per Bag
734.7 out of 5 Stars. 73 reviews
Save with
Nutrient Agar, 1.5% Nacl, Prepared Media Bottle, 125 Ml $11.30

$1130
current price $11.30Nutrient Agar, 1.5% Nacl, Prepared Media Bottle, 125 Ml
Nutrient Agar 100 grams $24.99

$2499
current price $24.99Nutrient Agar 100 grams
15 out of 5 Stars. 1 reviews
Nutrient Agar, Prepared Media Bottle,125 Ml, Plastic Bottle, No Autoclave Needed $11.65

$1165
current price $11.65Nutrient Agar, Prepared Media Bottle,125 Ml, Plastic Bottle, No Autoclave Needed
14 out of 5 Stars. 1 reviews
Nutrient Agar, 1.5%, Prepared Media Bottle, 125 Ml $11.30

$1130
current price $11.30Nutrient Agar, 1.5%, Prepared Media Bottle, 125 Ml
25 out of 5 Stars. 2 reviews
Nutrient Agar - Sterilized - 10, 100mm x 15mm Plates $29.99

$2999
current price $29.99Nutrient Agar - Sterilized - 10, 100mm x 15mm Plates
15 out of 5 Stars. 1 reviews
Nutrient Agar - Sterilized - 5, 100mm x 15mm Plates $16.99

$1699
current price $16.99Nutrient Agar - Sterilized - 5, 100mm x 15mm Plates
Nutrient Agar 10 grams (Dehydrated), Yields 435ml Solution (~14-16, 100mm Petri Dishes) $10.99

$1099
current price $10.99Nutrient Agar 10 grams (Dehydrated), Yields 435ml Solution (~14-16, 100mm Petri Dishes)
13 out of 5 Stars. 1 reviews
Agar Agar Powder 4 oz - Vegan Unflavored Gelatin Substitute - Nutrient Rich and Gluten Free - Fit Lane Nutrition $9.99

$999
current price $9.99Agar Agar Powder 4 oz - Vegan Unflavored Gelatin Substitute - Nutrient Rich and Gluten Free - Fit Lane Nutrition
254.6 out of 5 Stars. 25 reviews
Save with
Nutrient Agar Powder 100 Grams - Evviva Sciences - Makes Over 150 to 200 Agar Petri Dishes - Easy to Use - Great Science Fair Projects - W/Experiment Ebook $30.49

$3049
current price $30.49Nutrient Agar Powder 100 Grams - Evviva Sciences - Makes Over 150 to 200 Agar Petri Dishes - Easy to Use - Great Science Fair Projects - W/Experiment Ebook
15 out of 5 Stars. 1 reviews
Agar Agar Powder 8 oz - Vegan (Vegetarian) Gelatin - Gluten Free Unflavored - 151 Servings Per Bag $14.99 Was $16.99

Now$1499
current price Now $14.99, Was $16.99$16.99
Agar Agar Powder 8 oz - Vegan (Vegetarian) Gelatin - Gluten Free Unflavored - 151 Servings Per Bag
734.7 out of 5 Stars. 73 reviews
Save with
Nutrient Agar Kit, Includes Nutrient Agar Dehydrated, 10 Sterile Petri Dishes with Lids & 10 Sterile Cotton Swabs $18.99

$1899
current price $18.99Nutrient Agar Kit, Includes Nutrient Agar Dehydrated, 10 Sterile Petri Dishes with Lids & 10 Sterile Cotton Swabs
103.4 out of 5 Stars. 10 reviews
Best seller Nutritional Agar Plate 7cm Pre-Poured Petri Dishes for Microbiology Science Projects Easy to Use Nutrient Agar Plates for Lab Analysis $11.56 Was $19.19

Now$1156
current price Now $11.56, Was $19.19$19.19
Nutritional Agar Plate 7cm Pre-Poured Petri Dishes for Microbiology Science Projects Easy to Use Nutrient Agar Plates for Lab Analysis
24.5 out of 5 Stars. 2 reviews
Nutrient Agar Media Kit, All-Inclusive Kit, Perfect For Science Fair Projects $39.95

$3995
current price $39.95Nutrient Agar Media Kit, All-Inclusive Kit, Perfect For Science Fair Projects
204.3 out of 5 Stars. 20 reviews
BulkSupplements Agar Agar Powder, Food-Grade Thickener, Gluten-Free, 1kg, 250 Servings $14.97

$1497
current price $14.97BulkSupplements Agar Agar Powder, Food-Grade Thickener, Gluten-Free, 1kg, 250 Servings
84.3 out of 5 Stars. 8 reviews
Nutrient Agar Kit, Includes 20 Sterile Petri Dishes with Lids & 20 Sterile Cotton Swabs $26.99

$2699
current price $26.99Nutrient Agar Kit, Includes 20 Sterile Petri Dishes with Lids & 20 Sterile Cotton Swabs
15 out of 5 Stars. 1 reviews
Nutrient Agar Plates by Evviva Sciences - Prepoured Nutrient Agar Petri Dishes - Excellent Growth and Performance - A Great Science Kit for Science Fair Projects $30.99

$3099
current price $30.99Nutrient Agar Plates by Evviva Sciences - Prepoured Nutrient Agar Petri Dishes - Excellent Growth and Performance - A Great Science Kit for Science Fair Projects
15 out of 5 Stars. 1 reviews
Organic Agar Powder, 2 oz, Foods Alive - Agar Agar Powder, vegan gelatin substitute $14.57 $7.29/oz

$1457
current price $14.57$7.29/oz
Organic Agar Powder, 2 oz, Foods Alive - Agar Agar Powder, vegan gelatin substitute
53.2 out of 5 Stars. 5 reviews
Hoosier Hill Farm Agar Agar Powder, 1 lb Jar $29.99 Was $34.99

Now$2999
current price Now $29.99, Was $34.99$34.99
Hoosier Hill Farm Agar Agar Powder, 1 lb Jar
65 out of 5 Stars. 6 reviews
Save with
Raindrops 10 Pcs Petri Dish Agar Nutrient Agar Dish Nutrient Agar Plate 8.50X8.50X1.00CM $22.60

$2260
current price $22.60Raindrops 10 Pcs Petri Dish Agar Nutrient Agar Dish Nutrient Agar Plate 8.50X8.50X1.00CM
LOLIPPYY 10Pcs Nutrient Agar Plate Multi Agar Dishes for Educators $18.16

$1816
current price $18.16LOLIPPYY 10Pcs Nutrient Agar Plate Multi Agar Dishes for Educators
Nutrient Agar Broth Tubes, Pack of 12 - Sterile Microbiological Culture Media - The Curated Chemical Collection by Innovating Science $39.99

$3999
current price $39.99Nutrient Agar Broth Tubes, Pack of 12 - Sterile Microbiological Culture Media - The Curated Chemical Collection by Innovating Science
BulkSupplements Agar Agar Powder, Food-Grade Thickener, Gluten-Free, 500g, 125 Servings $29.97

$2997
current price $29.97BulkSupplements Agar Agar Powder, Food-Grade Thickener, Gluten-Free, 500g, 125 Servings
84.3 out of 5 Stars. 8 reviews
Save with
Laboratory-Grade Agar Powder, 500g - The Curated Chemical Collection $144.99

$14499
current price $144.99Laboratory-Grade Agar Powder, 500g - The Curated Chemical Collection
Raindrops 20 Pcs Nutrient Agar Plate Oven Experiment Pre Made for Science Baby Child $33.13

$3313
current price $33.13Raindrops 20 Pcs Nutrient Agar Plate Oven Experiment Pre Made for Science Baby Child
15 out of 5 Stars. 1 reviews
WHAMVOX 20 Pcs Nutrient Agar Plate Poured Pre Made for Science Child $27.62

$2762
current price $27.62WHAMVOX 20 Pcs Nutrient Agar Plate Poured Pre Made for Science Child
ROSENICE 20 Pcs Agar Plates for Experiment Nutrient Premium Material $35.49

$3549
current price $35.49ROSENICE 20 Pcs Agar Plates for Experiment Nutrient Premium Material
Agar Agar Powder 16 Ounces - Average Gel Strength $44.99

$4499
current price $44.99Agar Agar Powder 16 Ounces - Average Gel Strength
BulkSupplements Agar Agar Powder, Food-Grade Thickener, Gluten-Free, 250g, 63 Servings $19.97

$1997
current price $19.97BulkSupplements Agar Agar Powder, Food-Grade Thickener, Gluten-Free, 250g, 63 Servings
84.3 out of 5 Stars. 8 reviews
Save with
NOW Foods Agar Powder, 5 oz (142 g) $16.99

$1699
current price $16.99NOW Foods Agar Powder, 5 oz (142 g)
144.7 out of 5 Stars. 14 reviews
Raindrops 20 Pcs Science Nutrient Agar Plate Simple to Carry Plates Class Child $25.00

$2500
current price $25.00Raindrops 20 Pcs Science Nutrient Agar Plate Simple to Carry Plates Class Child
Aiva Agar Agar Powder 7 OZ | Vegan Gelatin Substitute, 100% Plant Based Thickener, Unflavore

Aiva Agar Agar Powder 7 OZ | Vegan Gelatin Substitute, 100% Plant Based Thickener, Unflavore
NatureJam Agar Agar Powder 1 Pound-Premium Gel Strength Gelatin Substitute For Vegans. $24.99

$2499
current price $24.99NatureJam Agar Agar Powder 1 Pound-Premium Gel Strength Gelatin Substitute For Vegans.
25 out of 5 Stars. 2 reviews
Save with
Naturejam Agar Agar Powder 8 Ounce Bag-Premium Gel Strength Gelatin Substitute for Vegans $14.99

$1499
current price $14.99Naturejam Agar Agar Powder 8 Ounce Bag-Premium Gel Strength Gelatin Substitute for Vegans
Save with
Pre-Poured Black Malt Extract Agar Plates Includes Both Black Dye & Charcoal for Enhanced Culture Visualization - Excellent Growth Medium - Great for Mushrooms & Science Projects$$Other $73.58
$7358
current price $73.58Pre-Poured Black Malt Extract Agar Plates Includes Both Black Dye & Charcoal for Enhanced Culture Visualization - Excellent Growth Medium - Great for Mushrooms & Science Projects$$Other
BulkSupplements Agar Agar Powder - Vegan Gelatin Alternative (1kg - 250 Servings) $43.97

$4397
current price $43.97BulkSupplements Agar Agar Powder - Vegan Gelatin Alternative (1kg - 250 Servings)
84.3 out of 5 Stars. 8 reviews
Save with
LOLIPPYY Agar Plates Pre-Poured with Nutrient for Science Fair Projects 10Pcs $19.84

$1984
current price $19.84LOLIPPYY Agar Plates Pre-Poured with Nutrient for Science Fair Projects 10Pcs
Agar Agar Powder 2oz - Excellent Gel Strength 900g/cm2 $11.99

$1199
current price $11.99Agar Agar Powder 2oz - Excellent Gel Strength 900g/cm2
264.5 out of 5 Stars. 26 reviews
Agar Agar Powder - 4 Ounces + 1 Bonus Ounce Free!!!, Excellent Gel Strength 900g/cm2 $22.99

$2299
current price $22.99Agar Agar Powder - 4 Ounces + 1 Bonus Ounce Free!!!, Excellent Gel Strength 900g/cm2
104.7 out of 5 Stars. 10 reviews
SUKA Agar-Agar Strip for Desserts & Sweets, 1.5 oz (42g) $21.99

$2199
current price $21.99SUKA Agar-Agar Strip for Desserts & Sweets, 1.5 oz (42g)
Agar Agar Powder 16oz 1 lb - Excellent Gel Strength 900g/cm2 $61.99

$6199
current price $61.99Agar Agar Powder 16oz 1 lb - Excellent Gel Strength 900g/cm2
15 out of 5 Stars. 1 reviews
Popular in Nutrient Agar
- Chemistry Phosfree
- Chemistry Buffer
- Water Treatment Chemistry
- Buffers Chemistry
- Mineral Identification Online Lab
- Biological Specimens
- PCR and Molecular Biology
- Anatomy Models
- Toxicology Chemistry Books
- Electron Microscopes & Microscopy Science Books
- Microscopes & Microscopy Science Books
- Electrochemistry Books
Related Products
Bromthymol Blue, 0.04% Aqueous, Laboratory Grade, 500 Ml
Bromthymol Blue, 0.04% Aqueous, Laboratory Grade, 500 Ml$7.85current price $7.85American Educational 40 Pieces Bundle Acid, Neutral, Base pH Test Paper
American Educational 40 Pieces Bundle Acid, Neutral, Base pH Test Paper$129.99current price $129.99Scientist Examining Chemical in a Test Tube Poster Print - 18 x 24 in.
Scientist Examining Chemical in a Test Tube Poster Print - 18 x 24 in.$40.25current price $40.25Abacus Brands Professor Maxwell's VR World Travel Kit - VR Atlas, Dino Dig STEM Toys, VR Goggles Included
Abacus Brands Professor Maxwell's VR World Travel Kit - VR Atlas, Dino Dig STEM Toys, VR Goggles Included$49.99current price $49.99Bio Plas 4051 2 ml G - Tube Flat Top Microcentrifuge Tube - 500 pk - Red
Bio Plas 4051 2 ml G - Tube Flat Top Microcentrifuge Tube - 500 pk - Red$26.23current price $26.23Abacus Brands Interactive Immersive Learning Volcano Lab VR Science Kit for Kids with VR Goggles
Abacus Brands Interactive Immersive Learning Volcano Lab VR Science Kit for Kids with VR Goggles$39.99current price $39.99Thames & Kosmos Chem C1000 Chemistry Set
Thames & Kosmos Chem C1000 Chemistry Set$77.60current price $77.60NICEXMAS 1pc Authentic Replica Professional Human Fatty Tissue Model Fat Model
NICEXMAS 1pc Authentic Replica Professional Human Fatty Tissue Model Fat Model$56.36current price $56.36Abacus Brands Virtual Reality History Set with DK Book, STEM Toys, VR Goggles Included
Abacus Brands Virtual Reality History Set with DK Book, STEM Toys, VR Goggles Included$49.99current price $49.99Bromthymol Blue, 0.04% Aqueous, Laboratory Grade, 100 Ml
Bromthymol Blue, 0.04% Aqueous, Laboratory Grade, 100 Ml$4.35current price $4.35Inktastic Future Scientist with Beakers, Test Tubes and Formulas Boys or Girls Toddler T-Shirt
Inktastic Future Scientist with Beakers, Test Tubes and Formulas Boys or Girls Toddler T-Shirt$17.99current price $17.99Practical Science Class Dna Model Double Strand Model For Gene Structure And Variation For Biology Experiments Education
Practical Science Class Dna Model Double Strand Model For Gene Structure And Variation For Biology Experiments Education$10.00current price $10.00Science Kit - Diffusion & Cell Size - For Teaching Volume To Diffusion Rate Relationship - Hands On Lab Activity - Materials for 5 Setups - Innovating Science
Science Kit - Diffusion & Cell Size - For Teaching Volume To Diffusion Rate Relationship - Hands On Lab Activity - Materials for 5 Setups - Innovating Science$35.99current price $35.99